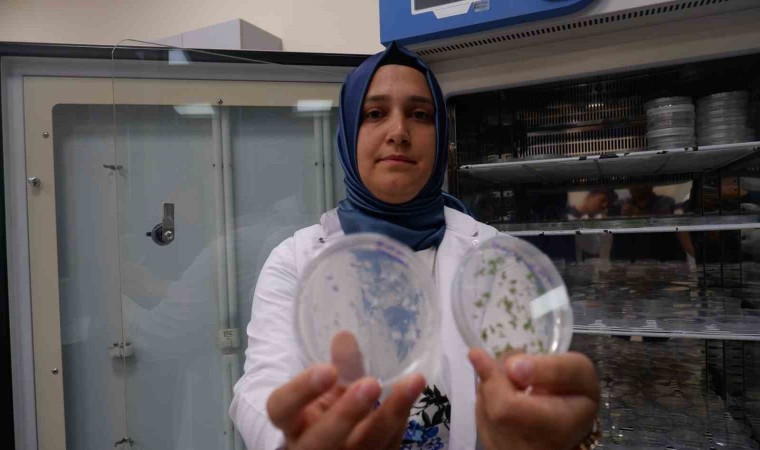

Erzurum Teknik Üniversitesi’nden Dr. Büşra Yazıcılar, topraktaki tuz stresini iyileştirme amacıyla D vitamini desteği verecek olana proje çalışmasında sona doğru geldi.
Ülkemizde son yıllarda tarımsal üretime dayalı alanlarda yerli ve milli, çalışmalar hız kazanırken, Erzurum Teknik Üniversitesi’nden (ETÜ), Dr. Büşra Yazıcılar, tuzlanarak verimini kaybeden toprakları geri kazanabilmek için bir proje geliştirdi. D vitamini kullanarak tuzlanan toprakları bereketlendirmeyi amaçladıklarını ifade eden, Yazıcılar, laboratuvar ortamında oluşturduğu yapay toprağa D vitamini uygulamasında başarılı sonuçlar aldıklarını anlattı.
“Ekili alanlarda verim artacak”
2026 yılında toprakla buluşması hedeflenen ve TÜBİTAK tarafından da desteklenen proje, ekili arazilerde verim artışında ciddi katkılar yapması bekleniyor. ETÜ Fen Fakültesi Molelüler Biyoloji ve Genetik Bölümü’nden 2012’de mezun olan Büşra Yazıcılar, 2018’de doktorasını tamamladı. Doktora sonrası post-doc çalışmasını sürdüren Büşra Yazıcılar, tuzlu arazileri tarıma geri kazandırmak için ’tuz stresini iyileştirmek amacıyla D vitamini uygulanması’ projesini hazırladı. ETÜ Yüksek Teknoloji Uygulama ve Araştırma Merkezi’nde yaklaşık (YÜTAM) bir yıl önce çalışmaya başlayan Yazıcılar, laboratuvar ortamında yapay toprak oluşturarak ekim yaptı ve D vitamini uyguladığı yapay toprakta tuzlanma oranının azaldığını tespit etti.
“Toprağa D vitamini desteği verecek”
Dr. Büşra Yazıcılar, tarımsal alanlarda tuzlanmayı azaltmak ve böylece hem verimi artırmak hem de ekili alanları artırmak için D vitamininin iyileştirici etkisini kullanmayı hedeflediğinin olduğunu vurgulayarak, "İnsan ve hayvanlar üzerinde kemik gelişiminde etkili olan D vitaminini toprak üzerinde de kullanmak istedik. Biz de bitki üzerinde hiç çalışma yapılmadığını tespit edince bu alanda denemeye karar verdik. Tarımda genellikle üreticiler tuzlu arazilerden muzdarip oluyor. Bu sorun geleceğin en önemli sıkıntısı. Biz de D vitamini uygulayarak tuzu elemine etmeye çalışarak tarlada bitki verimini ve kalitesini arttırmayı hedefledik. Böylece ekonomiye de katkı sağlamış olacağız" dedi.
D vitamini uygulamasını öncelikle küçük yapacaklarını ifade eden Yazıcılar, ekili arazilere D vitamini solüsyonu püskürteceğiz. Deneme tarlalarında başarılı olursak çiftçilerin ekonomisine katkı sağlayarak toprakların tuz oranını azaltmış olacağız" diye konuştu.

Yorum Yazın
E-posta hesabınız sitede yayımlanmayacaktır. Gerekli alanlar * ile işaretlenmişdir.